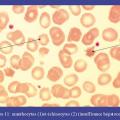
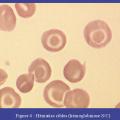

Image
Tumeurs du sein : inflammation et peau d'orange
TUMEURS DU SEIN
Image
Tumeurs du sein - Carcinome canalaire infiltrant
TUMEURS DU SEIN
CARCINOME CANALAIRE
Image
Tumeurs du sein - Cellules tumorales isolées
TUMEURS DU SEIN
Image
Tumeurs du sein - Cancer nodulaire chez une femme de 30 ans
TUMEURS DU SEIN
IMAGERIE PAR RESONANCE MAGNETIQUE
CARCINOME CANALAIRE
Image
Tumeurs du sein - Pièce de tumorectomie du sein droit
TUMEURS DU SEIN
Image
Mucormycose invasive rhino-sinusienne
MUCORMYCOSE
Image
Psoriasis unguéal
PSORIASIS
ONGLES
Image
Neuropathie optique aiguë
OEDEME PAPILLAIRE
Image
Pachyméningite sous-tentorielle
MENINGITE
Image
Œdème papillaire bilatéral
OEDEME PAPILLAIRE
HYPERTENSION INTRACRANIENNE
Image
Paralysie oculomotrice de la 6e paire crânienne droite
OPHTALMOPLEGIE
Image
Pancréatite aiguë
NECROSE
PANCREATITE
Image
Gonarthrose post traumatique
GONARTHROSE
Image
Gonarthrose
GONARTHROSE
Image
Rhizarthrose
ARTHROSE
POUCE
Image
Lésion chondrale profonde
GONARTHROSE
CARTILLAGE ARTICULAIRE
GENOU
Image
Gonarthrose
GENOU
GONALGIE
Image
Omarthrose centrée
ARTHROSE
EPAULE
Image
Acanthocytes et échinocytes (insuffisance hépatocellulaire)
ERYTHROCYTES ANORMAUX
ACANTHOCYTES
Image
Hématies cibles (hémoglobinose S/C)
ERYTHROCYTES ANORMAUX
Image
Leishmaniose cutanée
LEISHMANIOSE CUTANE
Image
Tungose d'un orteil
TUNGOSE
Image
Chéilite actinique chronique
CHEILITE ACTINIQUE
LEVRES
Image